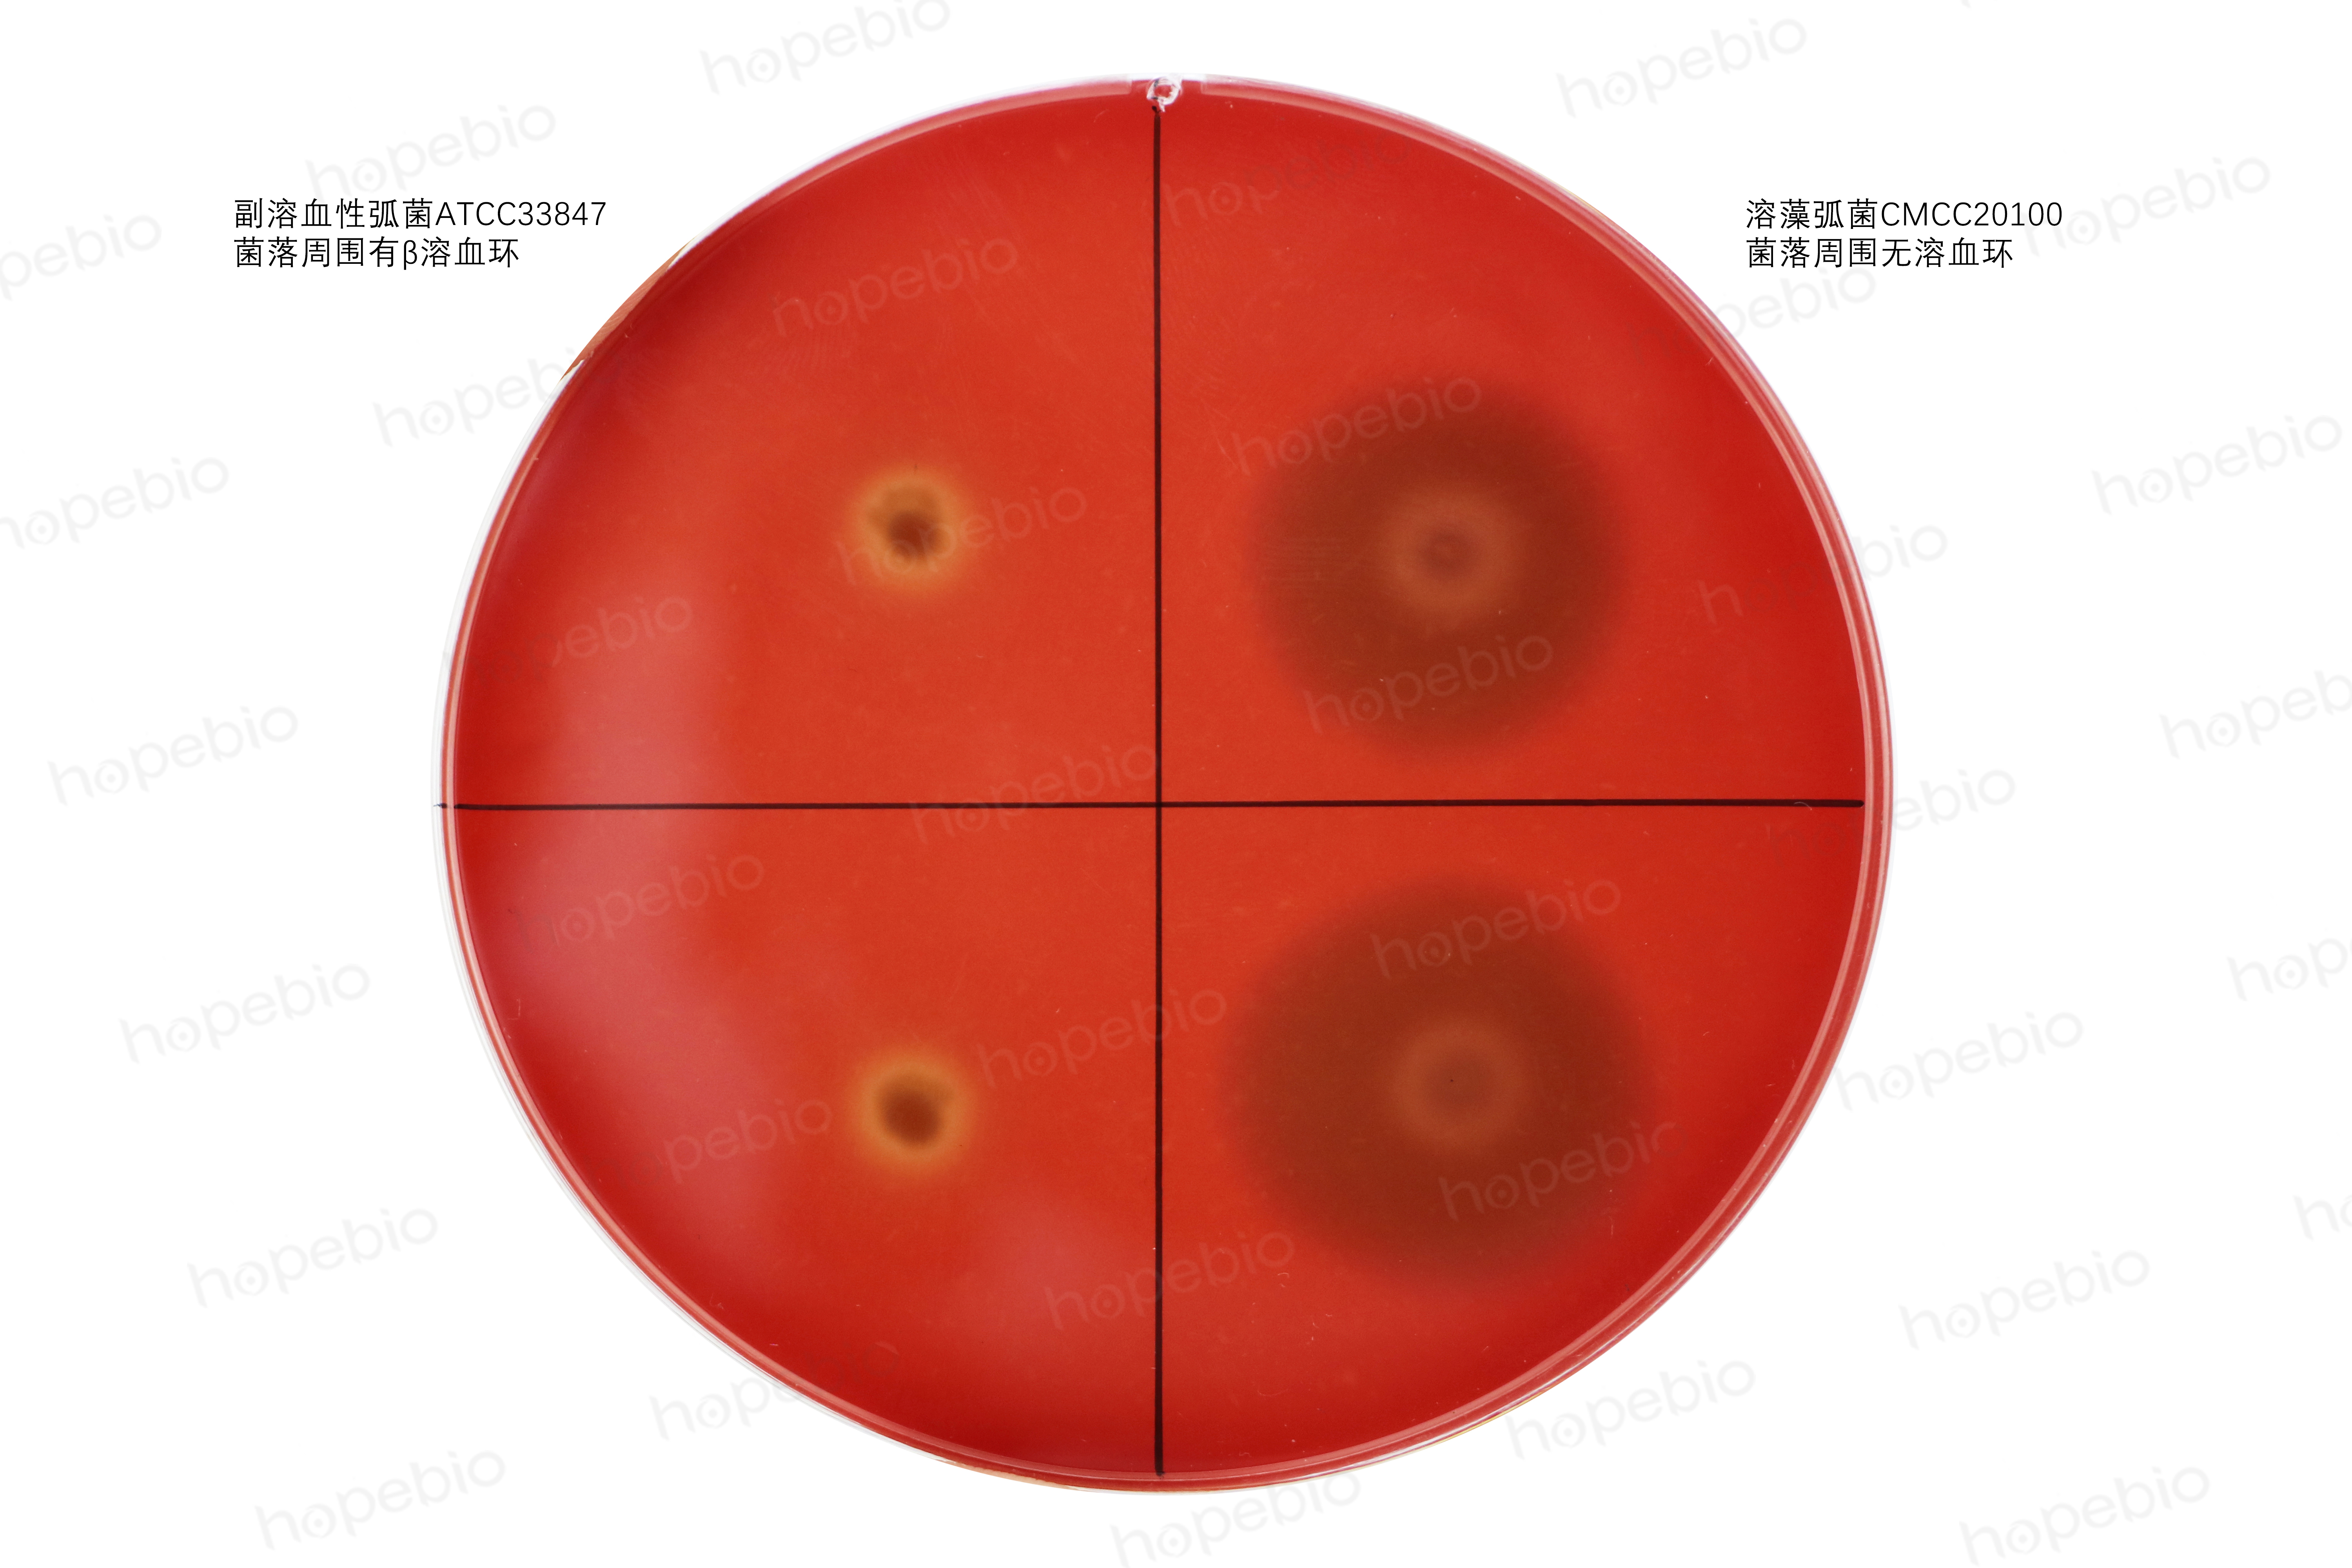
神奈川试验,神奈川实验谁发现的

一、 试验原理
副溶血性弧菌在普通血平板上不溶血或只产生α溶血。但在特定条件下,某些菌株在含高盐(7%)的人O型血或兔血以及D-甘露醇做为碳源的我妻氏琼脂平板上可产生β溶血,称为神奈川现象。
神奈川试验结果与副溶血性弧菌的致病性显著相关,该试验常用来判断菌株的毒力强弱。副溶血性弧菌有845个血清型,主要通过十三种耐热的菌体抗原(即O抗原)鉴定,而七种不耐热的包膜抗原(即K抗原)可以用来辅助鉴定。其致病力可用神奈川试验来区分。神奈川试验阳性菌的感染能力强,多数毒性菌株为神奈川试验阳性(K+),多数非毒性菌株为神奈川试验阴性(Kˉ)。引起食物中毒的副溶血性弧菌90%神奈川试验阳性,通常在12h内出现症状。K+菌株能产生一种耐热型直接溶血素,Kˉ菌株能产生一种热敏型溶血素,而有些菌株能产生这两种溶血素。
培养基中的蛋白胨和酵母粉提供营养;磷酸氢二钾为pH缓冲剂;7%含量的氯化钠及甘露醇做为碳源,为副溶血性弧菌溶血现象提供条件;结晶紫可抑制部分耐盐性、β溶血的葡萄球菌的生长,琼脂为凝固剂。
二、 培养基成分及使用方法:
1. 培养基成分
|
成分 |
含量(g/L) |
|
蛋白胨 |
10.0 |
|
酵母浸粉 |
3.0 |
|
氯化钠 |
70.0 |
|
磷酸氢二钾 |
5.0 |
|
甘露醇 |
10.0 |
|
结晶紫 |
0.001 |
|
琼脂 |
15.0 |
|
pH 8.0±0.1 25℃ |
|
2. 使用方法
称取本品 11.3g,加热溶解于100ml蒸馏水中。加热至100℃保持30分钟(可沸水浴30min)。冷却至50℃左右时,按5%的体积加入新鲜兔血球,充分摇匀,倾注无菌平板备用。
三、 质控方法
1、按使用方法制备培养基,用接种环挑取以下质控菌株固体培养物点种于表面干燥的平板,于37℃需氧培养18-24小时。
|
质控菌株 |
菌株编号 |
接种量(CFU) |
生长情况 |
其他特征 |
|
大肠杆菌 |
ATCC25922 |
/ |
+++ |
无溶血 |
|
金黄色葡萄球菌 |
ATCC25923 |
/ |
+++ |
无溶血 |
|
溶藻弧菌 |
ATCC17749 |
/ |
+++ |
无溶血 |
|
副溶血性弧菌 |
ATCC33847 |
/ |
+++ |
菌落周围有半透明β溶血环 |
2、副溶血性弧菌和溶藻弧菌在培养基上的生长情况如下图所示:
副溶血性弧菌菌落周围有透明的β溶血环,溶藻弧菌菌落周围无溶血环。
四、注意事项
在制备培养基的过程中,添加兔血球时,应先将兔血球溶液预热至40-50℃左右,再加入至冷却至50℃左右的培养基中。若二者温差过大,易在培养基中产生凝块;加入兔血球后应轻轻摇匀倒平板,若摇晃幅度过大易出现大量气泡,倒出的平板不平整;平板不宜过厚,2-3mm为宜,方便观察溶血环。
注:本文属海博生物原创,未经允许不得转载。